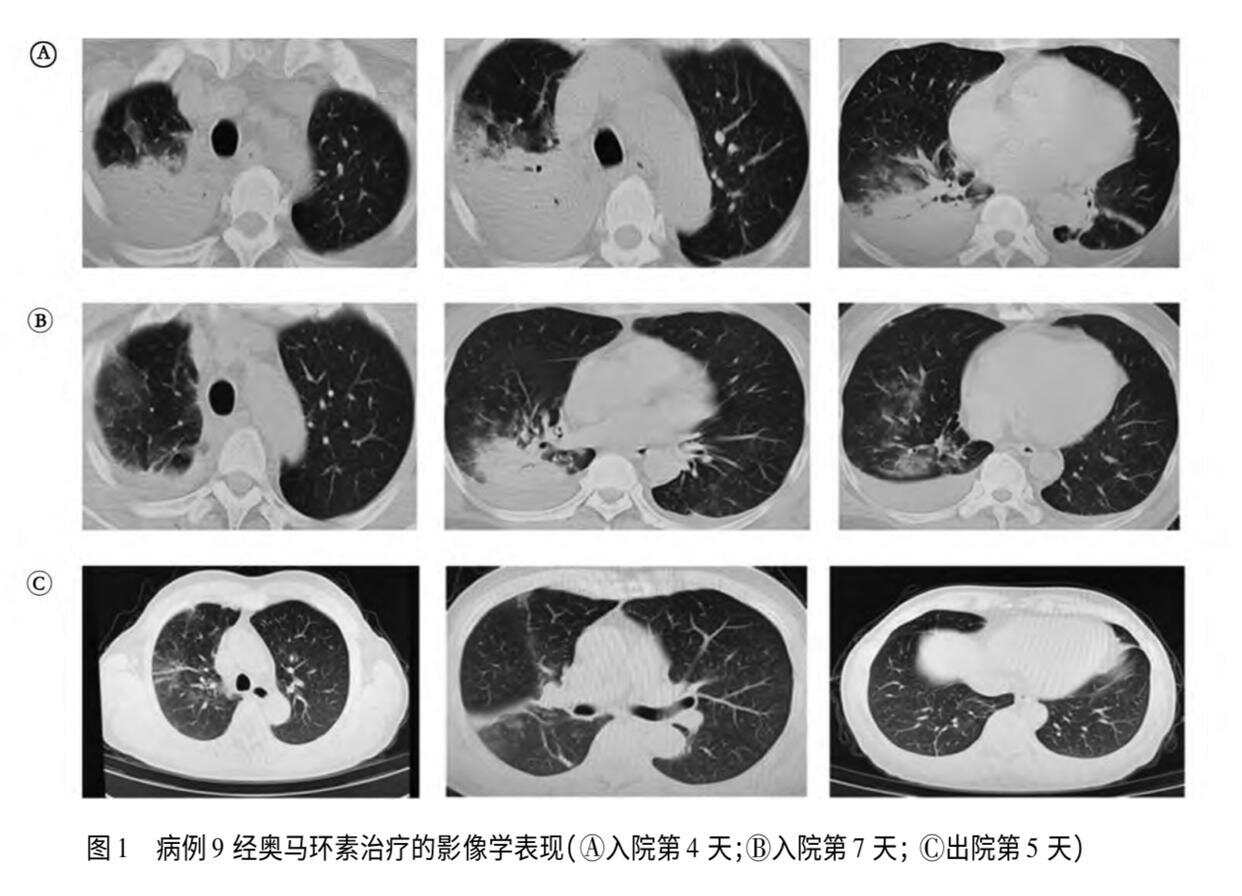

近年来,五颜六色、聪明黏人的小鹦鹉正成为都市家庭的新宠。在出诊时,医生李冉偶尔会被患者秀一下手机里的宝贝小鸟,与此同时,鹦鹉热患者也多了起来。
这一人畜共患病,可以从鹦鹉、信鸽等动物传染给人类,轻者发烧、头痛,重者肺炎入院,甚至需要上呼吸机。
据北京市疾控中心统计,2023年-2024年北京共报告了64例鹦鹉热病例。贵州、南京、淮安、武汉等多地亦有相关报道。
小鸟病了,主人也病了
不久前,一个年轻姑娘来到北京朝阳医院感染科副主任医师李冉的诊室,坐下就说自己养了鸟,最近发烧多日,但吃药不见效,怀疑自己是被小鸟感染了——她在宠物医院给鸟做了检测,鸟儿确诊为鹦鹉热,该患者后来也确诊为鹦鹉热。
鹦鹉热,由鹦鹉热衣原体(Chlamydia psittaci)引起,是一种人畜共患病,人可通过吸入含病原体的气溶胶或接触被污染的鸟类排泄物、羽毛而感染。1879年,欧洲首次报道了与接触鹦鹉和金丝雀有关的人类致命性呼吸道疾病,1894年,确认该病原体可由鹦鹉传人,鹦鹉热由此得名。
“大概从2025年开始,我们门诊就常常收到鹦鹉热病例,其中大多能找到流行病学史,要么是养了小鸟,要么是帮着照顾小鸟,或去市场接触了小鸟,也有接触鸟类粪便感染的。”李冉告诉记者。
小鸟感冒,主人也跟着生病,已不是什么稀奇事。记者检索专业资料库发现,贵州、南京、淮安、武汉、绍兴、杭州、北京等多地医疗机构均曾接诊过鹦鹉热病例。
今年3月,中国科学院微生物研究所与航空总医院发布论文,介绍了北京两例因感染鹦鹉热发生肺炎的女性病例,两人在出现症状前均购买了宠物鹦鹉,这些鹦鹉到家后不久便出现了精神萎靡、羽毛蓬松、呼吸困难等症状,并最终死亡;今年2月,安徽一男子购入4只鹦鹉当宠物,随后3只莫名死亡,家人也陆续出现发热等症状。
北京市疾控部门对鹦鹉热进行了较为系统的研究。在《2023-2024年北京市鹦鹉热临床和流行病学特征研究》一文中提到,2020年北京市报告了本市首例鹦鹉热病例,之后每年报告病例数逐渐上升。2023-2024年间,北京市共报告鹦鹉热病例64例,报告病例分布在北京的11个区,其中2024年报告病例数较多,为45例。其中,多数病例存在鸟类饲养史。
在北京市大兴区一起鹦鹉热聚集性疫情的流调分析中提到,大兴区自2021年接报首例鹦鹉热病例以来,报告病例数逐年增多。2021年国家林业和草原局发布《关于妥善解决人工繁育鹦鹉有关问题的函》,鼓励合法养殖,且人工可饲养鹦鹉种类增多,加之mNGS检测的广泛应用,越来越多的少见病可被快速检测,鹦鹉热病例也随之增多。
从饲养到接触粪便,鹦鹉热如何传播?
据悉,人感染鹦鹉热衣原体主要通过接触鸟类,或者吸入这些鸟类或者禽类的粪便、尿液、呼吸道分泌物等产生的气溶胶,且人群普遍易感。
李冉分享了几个印象深刻的病例。
一对老夫妻,帮助照顾孩子家的鹦鹉。老头先病了,因身体硬朗、没有基础病,很快出院;没过两天,老太太也病了,由于有基础病,症状持续加重,进展为重症肺炎,上了呼吸机,入院治疗一段时间后痊愈出院。
一位母亲帮孩子养鹦鹉,不久生病了,叫自己的姐妹去照顾小鸟,姐妹也生病了,两人前后脚来看病。
一位养了几年鹦鹉的市民,因朋友家新来的小鹦鹉老跟“原住民”打架,帮着寄养了几天,后来小鹦鹉感冒了,他也“感冒”了。
这些患者大多有明确的鸟类饲养史,但也有没有直接接触便感染的。今年春节,北京一位老太太和家人去逛花鸟市场,家人都没事,老太太却感染鹦鹉热发生肺炎;还有一位小学保安,不养鸟,也不去花鸟市场,仅是收拾过院子里的鸟粪,因此被感染。
上述北京市疾控的流调分析中提到,64例报告病例中,39例(占60.94%)病例家饲养宠物鸟,2例病例从事(鸽子)饲养工作,1例病例仅饲养家禽(鸭、鹅)。22例病例否认饲养鸟类,其中10例病例明确记得家庭住址或工作单位附近有人饲养鸟类(鹦鹉、鸽子等),其余12例病例否认与家养鸟类有接触史。
值得注意的是,鹦鹉热不光只有鹦鹉可传播。一篇由中日友好医院团队发表的鹦鹉热衣原体的研究进展中指出,鹦鹉热衣原体常见宿主类型包括鹦鹉科鸟类、鸽子、鸭等水禽、火鸡、啮齿动物、牛,易感人群包括禽类饲养者、动物园工作者、宠物店工作者、屠宰场工人、野生动物研究者及医务工作者、家属等密接者。
武汉2024年一起鹦鹉热聚集性疫情中,既有信鸽饲养者感染,也有住在该饲养者下层的邻居被感染。疾控分析认为,两者上下楼阳台之间无物理隔断,养殖户家中信鸽排泄物、分泌物和羽毛等直接污染了楼下邻居阳台周边环境,该邻居在阳台躺椅午休、乘凉时吸入感染鹦鹉热衣原体鸽子的干燥排泄物微粒、分泌物或羽毛尘埃而感染发病的可能性极大。
抗感染治疗为主,部分患者需上呼吸机
中日友好医院团队的论文中提到,鹦鹉热衣原体因其特殊的致病机制可导致全身多系统症状,其中以呼吸系统症状为主,同时可出现神经系统、消化系统等症状。鹦鹉热起病隐匿,且无特征性症状,平均潜伏期 5~14 天,呼吸道症状可表现为轻症,如发热、头疼、咳嗽、乏力、食欲不振等流感样症状,也可出现危及生命的重症肺炎、急性呼吸窘迫综合征以及呼吸衰竭等,研究显示轻症和重症鹦鹉热肺炎患者均有发热,但重症鹦鹉热肺炎的体温高峰高于非重症鹦鹉热肺炎,重症鹦鹉热肺炎以咳嗽、咳痰、呼吸困难等症状多见。
部分鹦鹉热患者可合并神经系统症状,如头疼、头晕、谵妄、共济失调、意识模糊、意识障碍、语言障碍、脑膜炎、癫痫、急性炎症性脱髓鞘性多发性神经病等。最新的研究显示突发性神经性听力损失也可作为鹦鹉热患者的首发症状。
“从我们的接诊经验看,鹦鹉热感染大多是轻症,预后不错。”李冉介绍,其治疗方法主要是抗感染治疗,四环素类、喹诺酮类等抗生素有效。
但值得注意的是,由于鹦鹉热发病症状不典型,加之其知晓率不高,很多饲主在感染后不容易意识到,导致病情加重了才前往医院,其中一部分进展为肺炎。此外,对于免疫力低下群体,如老年人、基础病患者,不仅更容易感染,且发病后风险更高。
此外,有少部分鹦鹉携带病原体但没有表现,属于“无症状感染者”。因此,打算养鹦鹉的家庭,若有条件,可以先对鹦鹉进行检测。
怎样预防鹦鹉热
1.外出时避免近距离接触野生鸟禽类,与其保持一定距离。
2.购买正规渠道、检疫健康的禽鸟,切勿购买来历不明或可疑发病的宠物。
3.可以在新购入的鸟类食物中添加四环素、红霉素进行预防,尤其是在家禽和鸟类运输前后。
4.饲养鸟类宠物人员注意保持笼器的干燥清洁,定时消毒。
5.在接触饲养的禽类时,需注意卫生,在处理排泄物时,应做好个人防护,规范戴口罩、戴手套,处理后及时洗手。若被抓咬挠伤则需及时消毒清洁伤口,必要时就医咨询。
6.鸟禽宠物如有可疑症状,及时寻求专业宠物医生帮助;若自身出现相应的临床症状,且有鸟禽暴露史,应及时前往医院就诊,并告知医生相关流行病学史。
(羊城晚报•羊城派综合自新京报、毕节市卫生健康局)
近年来,五颜六色、聪明黏人的小鹦鹉正成为都市家庭的新宠。在出诊时,医生李冉偶尔会被患者秀一下手机里的宝贝小鸟,与此同时,鹦鹉热患者也多了起来。
这一人畜共患病,可以从鹦鹉、信鸽等动物传染给人类,轻者发烧、头痛,重者肺炎入院,甚至需要上呼吸机。
据北京市疾控中心统计,2023年-2024年北京共报告了64例鹦鹉热病例。贵州、南京、淮安、武汉等多地亦有相关报道。
小鸟病了,主人也病了
不久前,一个年轻姑娘来到北京朝阳医院感染科副主任医师李冉的诊室,坐下就说自己养了鸟,最近发烧多日,但吃药不见效,怀疑自己是被小鸟感染了——她在宠物医院给鸟做了检测,鸟儿确诊为鹦鹉热,该患者后来也确诊为鹦鹉热。
鹦鹉热,由鹦鹉热衣原体(Chlamydia psittaci)引起,是一种人畜共患病,人可通过吸入含病原体的气溶胶或接触被污染的鸟类排泄物、羽毛而感染。1879年,欧洲首次报道了与接触鹦鹉和金丝雀有关的人类致命性呼吸道疾病,1894年,确认该病原体可由鹦鹉传人,鹦鹉热由此得名。
“大概从2025年开始,我们门诊就常常收到鹦鹉热病例,其中大多能找到流行病学史,要么是养了小鸟,要么是帮着照顾小鸟,或去市场接触了小鸟,也有接触鸟类粪便感染的。”李冉告诉记者。
小鸟感冒,主人也跟着生病,已不是什么稀奇事。记者检索专业资料库发现,贵州、南京、淮安、武汉、绍兴、杭州、北京等多地医疗机构均曾接诊过鹦鹉热病例。
今年3月,中国科学院微生物研究所与航空总医院发布论文,介绍了北京两例因感染鹦鹉热发生肺炎的女性病例,两人在出现症状前均购买了宠物鹦鹉,这些鹦鹉到家后不久便出现了精神萎靡、羽毛蓬松、呼吸困难等症状,并最终死亡;今年2月,安徽一男子购入4只鹦鹉当宠物,随后3只莫名死亡,家人也陆续出现发热等症状。
北京市疾控部门对鹦鹉热进行了较为系统的研究。在《2023-2024年北京市鹦鹉热临床和流行病学特征研究》一文中提到,2020年北京市报告了本市首例鹦鹉热病例,之后每年报告病例数逐渐上升。2023-2024年间,北京市共报告鹦鹉热病例64例,报告病例分布在北京的11个区,其中2024年报告病例数较多,为45例。其中,多数病例存在鸟类饲养史。
在北京市大兴区一起鹦鹉热聚集性疫情的流调分析中提到,大兴区自2021年接报首例鹦鹉热病例以来,报告病例数逐年增多。2021年国家林业和草原局发布《关于妥善解决人工繁育鹦鹉有关问题的函》,鼓励合法养殖,且人工可饲养鹦鹉种类增多,加之mNGS检测的广泛应用,越来越多的少见病可被快速检测,鹦鹉热病例也随之增多。
从饲养到接触粪便,鹦鹉热如何传播?
据悉,人感染鹦鹉热衣原体主要通过接触鸟类,或者吸入这些鸟类或者禽类的粪便、尿液、呼吸道分泌物等产生的气溶胶,且人群普遍易感。
李冉分享了几个印象深刻的病例。
一对老夫妻,帮助照顾孩子家的鹦鹉。老头先病了,因身体硬朗、没有基础病,很快出院;没过两天,老太太也病了,由于有基础病,症状持续加重,进展为重症肺炎,上了呼吸机,入院治疗一段时间后痊愈出院。
一位母亲帮孩子养鹦鹉,不久生病了,叫自己的姐妹去照顾小鸟,姐妹也生病了,两人前后脚来看病。
一位养了几年鹦鹉的市民,因朋友家新来的小鹦鹉老跟“原住民”打架,帮着寄养了几天,后来小鹦鹉感冒了,他也“感冒”了。
这些患者大多有明确的鸟类饲养史,但也有没有直接接触便感染的。今年春节,北京一位老太太和家人去逛花鸟市场,家人都没事,老太太却感染鹦鹉热发生肺炎;还有一位小学保安,不养鸟,也不去花鸟市场,仅是收拾过院子里的鸟粪,因此被感染。
上述北京市疾控的流调分析中提到,64例报告病例中,39例(占60.94%)病例家饲养宠物鸟,2例病例从事(鸽子)饲养工作,1例病例仅饲养家禽(鸭、鹅)。22例病例否认饲养鸟类,其中10例病例明确记得家庭住址或工作单位附近有人饲养鸟类(鹦鹉、鸽子等),其余12例病例否认与家养鸟类有接触史。
值得注意的是,鹦鹉热不光只有鹦鹉可传播。一篇由中日友好医院团队发表的鹦鹉热衣原体的研究进展中指出,鹦鹉热衣原体常见宿主类型包括鹦鹉科鸟类、鸽子、鸭等水禽、火鸡、啮齿动物、牛,易感人群包括禽类饲养者、动物园工作者、宠物店工作者、屠宰场工人、野生动物研究者及医务工作者、家属等密接者。
武汉2024年一起鹦鹉热聚集性疫情中,既有信鸽饲养者感染,也有住在该饲养者下层的邻居被感染。疾控分析认为,两者上下楼阳台之间无物理隔断,养殖户家中信鸽排泄物、分泌物和羽毛等直接污染了楼下邻居阳台周边环境,该邻居在阳台躺椅午休、乘凉时吸入感染鹦鹉热衣原体鸽子的干燥排泄物微粒、分泌物或羽毛尘埃而感染发病的可能性极大。
抗感染治疗为主,部分患者需上呼吸机
中日友好医院团队的论文中提到,鹦鹉热衣原体因其特殊的致病机制可导致全身多系统症状,其中以呼吸系统症状为主,同时可出现神经系统、消化系统等症状。鹦鹉热起病隐匿,且无特征性症状,平均潜伏期 5~14 天,呼吸道症状可表现为轻症,如发热、头疼、咳嗽、乏力、食欲不振等流感样症状,也可出现危及生命的重症肺炎、急性呼吸窘迫综合征以及呼吸衰竭等,研究显示轻症和重症鹦鹉热肺炎患者均有发热,但重症鹦鹉热肺炎的体温高峰高于非重症鹦鹉热肺炎,重症鹦鹉热肺炎以咳嗽、咳痰、呼吸困难等症状多见。
部分鹦鹉热患者可合并神经系统症状,如头疼、头晕、谵妄、共济失调、意识模糊、意识障碍、语言障碍、脑膜炎、癫痫、急性炎症性脱髓鞘性多发性神经病等。最新的研究显示突发性神经性听力损失也可作为鹦鹉热患者的首发症状。
“从我们的接诊经验看,鹦鹉热感染大多是轻症,预后不错。”李冉介绍,其治疗方法主要是抗感染治疗,四环素类、喹诺酮类等抗生素有效。
但值得注意的是,由于鹦鹉热发病症状不典型,加之其知晓率不高,很多饲主在感染后不容易意识到,导致病情加重了才前往医院,其中一部分进展为肺炎。此外,对于免疫力低下群体,如老年人、基础病患者,不仅更容易感染,且发病后风险更高。
此外,有少部分鹦鹉携带病原体但没有表现,属于“无症状感染者”。因此,打算养鹦鹉的家庭,若有条件,可以先对鹦鹉进行检测。
怎样预防鹦鹉热
1.外出时避免近距离接触野生鸟禽类,与其保持一定距离。
2.购买正规渠道、检疫健康的禽鸟,切勿购买来历不明或可疑发病的宠物。
3.可以在新购入的鸟类食物中添加四环素、红霉素进行预防,尤其是在家禽和鸟类运输前后。
4.饲养鸟类宠物人员注意保持笼器的干燥清洁,定时消毒。
5.在接触饲养的禽类时,需注意卫生,在处理排泄物时,应做好个人防护,规范戴口罩、戴手套,处理后及时洗手。若被抓咬挠伤则需及时消毒清洁伤口,必要时就医咨询。
6.鸟禽宠物如有可疑症状,及时寻求专业宠物医生帮助;若自身出现相应的临床症状,且有鸟禽暴露史,应及时前往医院就诊,并告知医生相关流行病学史。
(羊城晚报•羊城派综合自新京报、毕节市卫生健康局)
OCR:新闻 加点料
OCR:A Symptom Miconazole nitrate Hospital Purchase: onset: Purchase: Symptom 3parrots 3parots Paracetamol Azithromycin Fever visit Euthanasia& Death Death 1parrot onset dissection Moxifloxacin Recovery 4年年 福福临 Sanitization Melopsittacus M.undulatus K Patient 1 Patient 1 T Mar Mar Mar Mar Apr APr AP Time A0r 21-23 22 24-27 AB Location Annu (night) Henan B Hospital visit Paracetamol tablets & Chuanxinlian Neizhi Dripping Pills & Purchase: Oseltamivir capsules&Peramivir injection 1parrot Symptom onset Feve Sampling Death Recovery Nymphicus loWandicu: Patient 2 Patient2 Patient2 Beg25 Sep 1 Sep7 中 Sep8 Sep 9 Sep 10 Sep 17 C L X12647_E Human AY762611_E Pigeon AB284062_E/B Human AY762613_E/B Duck AY762609_B Turkey AF269265_B EU159263.1_B Pigeon X56980.1_A 100mm Y16561_A Parrot AF269281_A EU856023.1_C Duck 日 Parrot_e_oralswab Parrot Patient_2_sputum Sample source Human Host PCRresult Accession number 0.03 CP025423 Parrot Patient 1 sputum Human Positive NMDCN00091J1 CP002807_A DQ324426_A Human Patient 2 sputum 100 Human Positive NMDCN00091J2 AB284058_Mat116 Parot Parot c lung Parrot Positive NMDCN00091IP AF269268_M56 Muskrat 100 AF269261_D Parrot c turbinate Parrot Positive NMDCN00091IQ L25436_C Duck AB284065_Daruma Parrot Parrot c spleen Parrot Positive NMDCN00091IR AJ243525_R54 Parrot Skua Parrot d lung Parrot Positive NMDCN00091IS 99 100 AF269259_F AY762612_F Duck Parrot d turbinate Parrot Positive NMDCN00091IT EF028916_1V Corvus Parrot d spleen Parrot Positive NMDCN00091IU AF269266_D Turkey EF375557_9N Parrot Positive NMDCN00091J0 EF197820_6N Corvus Parrot e oral swab Positive AF269269_WC Parrot e cloacal swab Parrot NMDCN00091IV Cow AB284064_CPX0308 Stork H 500
OCR:A B C 图1病例9经奥马环素治疗的影像学表现(A入院第4天;B入院第7天;C出院第5天)
OCR:新闻 加点料